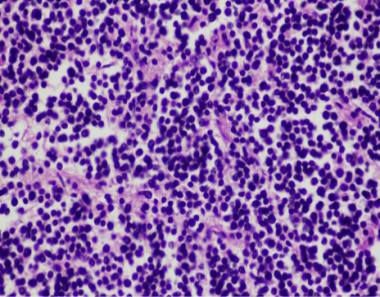

Research Journal for Veterinary Practitioners
Multilobulated splenic mass 5x5x5 cm in size, white, and firm consistency
Multifocal dystrophic calcification at the endocardium of heart (HE stain, mag 40x)
Metastatic glomerular and tubular basement calcification of kidney (HE stain, mag 40x)
Lymph node consisted of mainly lymphoblasts and expanded lymphoid follicles. The tumor were small round cells with hyperchromatic round nuclei (HE stain, mag 40x)
Splenic mass consisted of expanded follicular pattern and solid sheets of lymphoblasts attached at fibrotic splenic capsule (HE stain, mag 10x, 40x)
Intense positive staining of CD79α (B-cell marker) of lymphoblasts in lymphadenopathy (LSAB, DAB counterstained with Mayer’s Hematoxylin, mag 40x)
Negative staining of CD3 (T-cell marker) of lymphoblasts in splenic mass (IHC, LSAB, DAB counterstained with Mayer’s Hematoxylin, mag 40x)